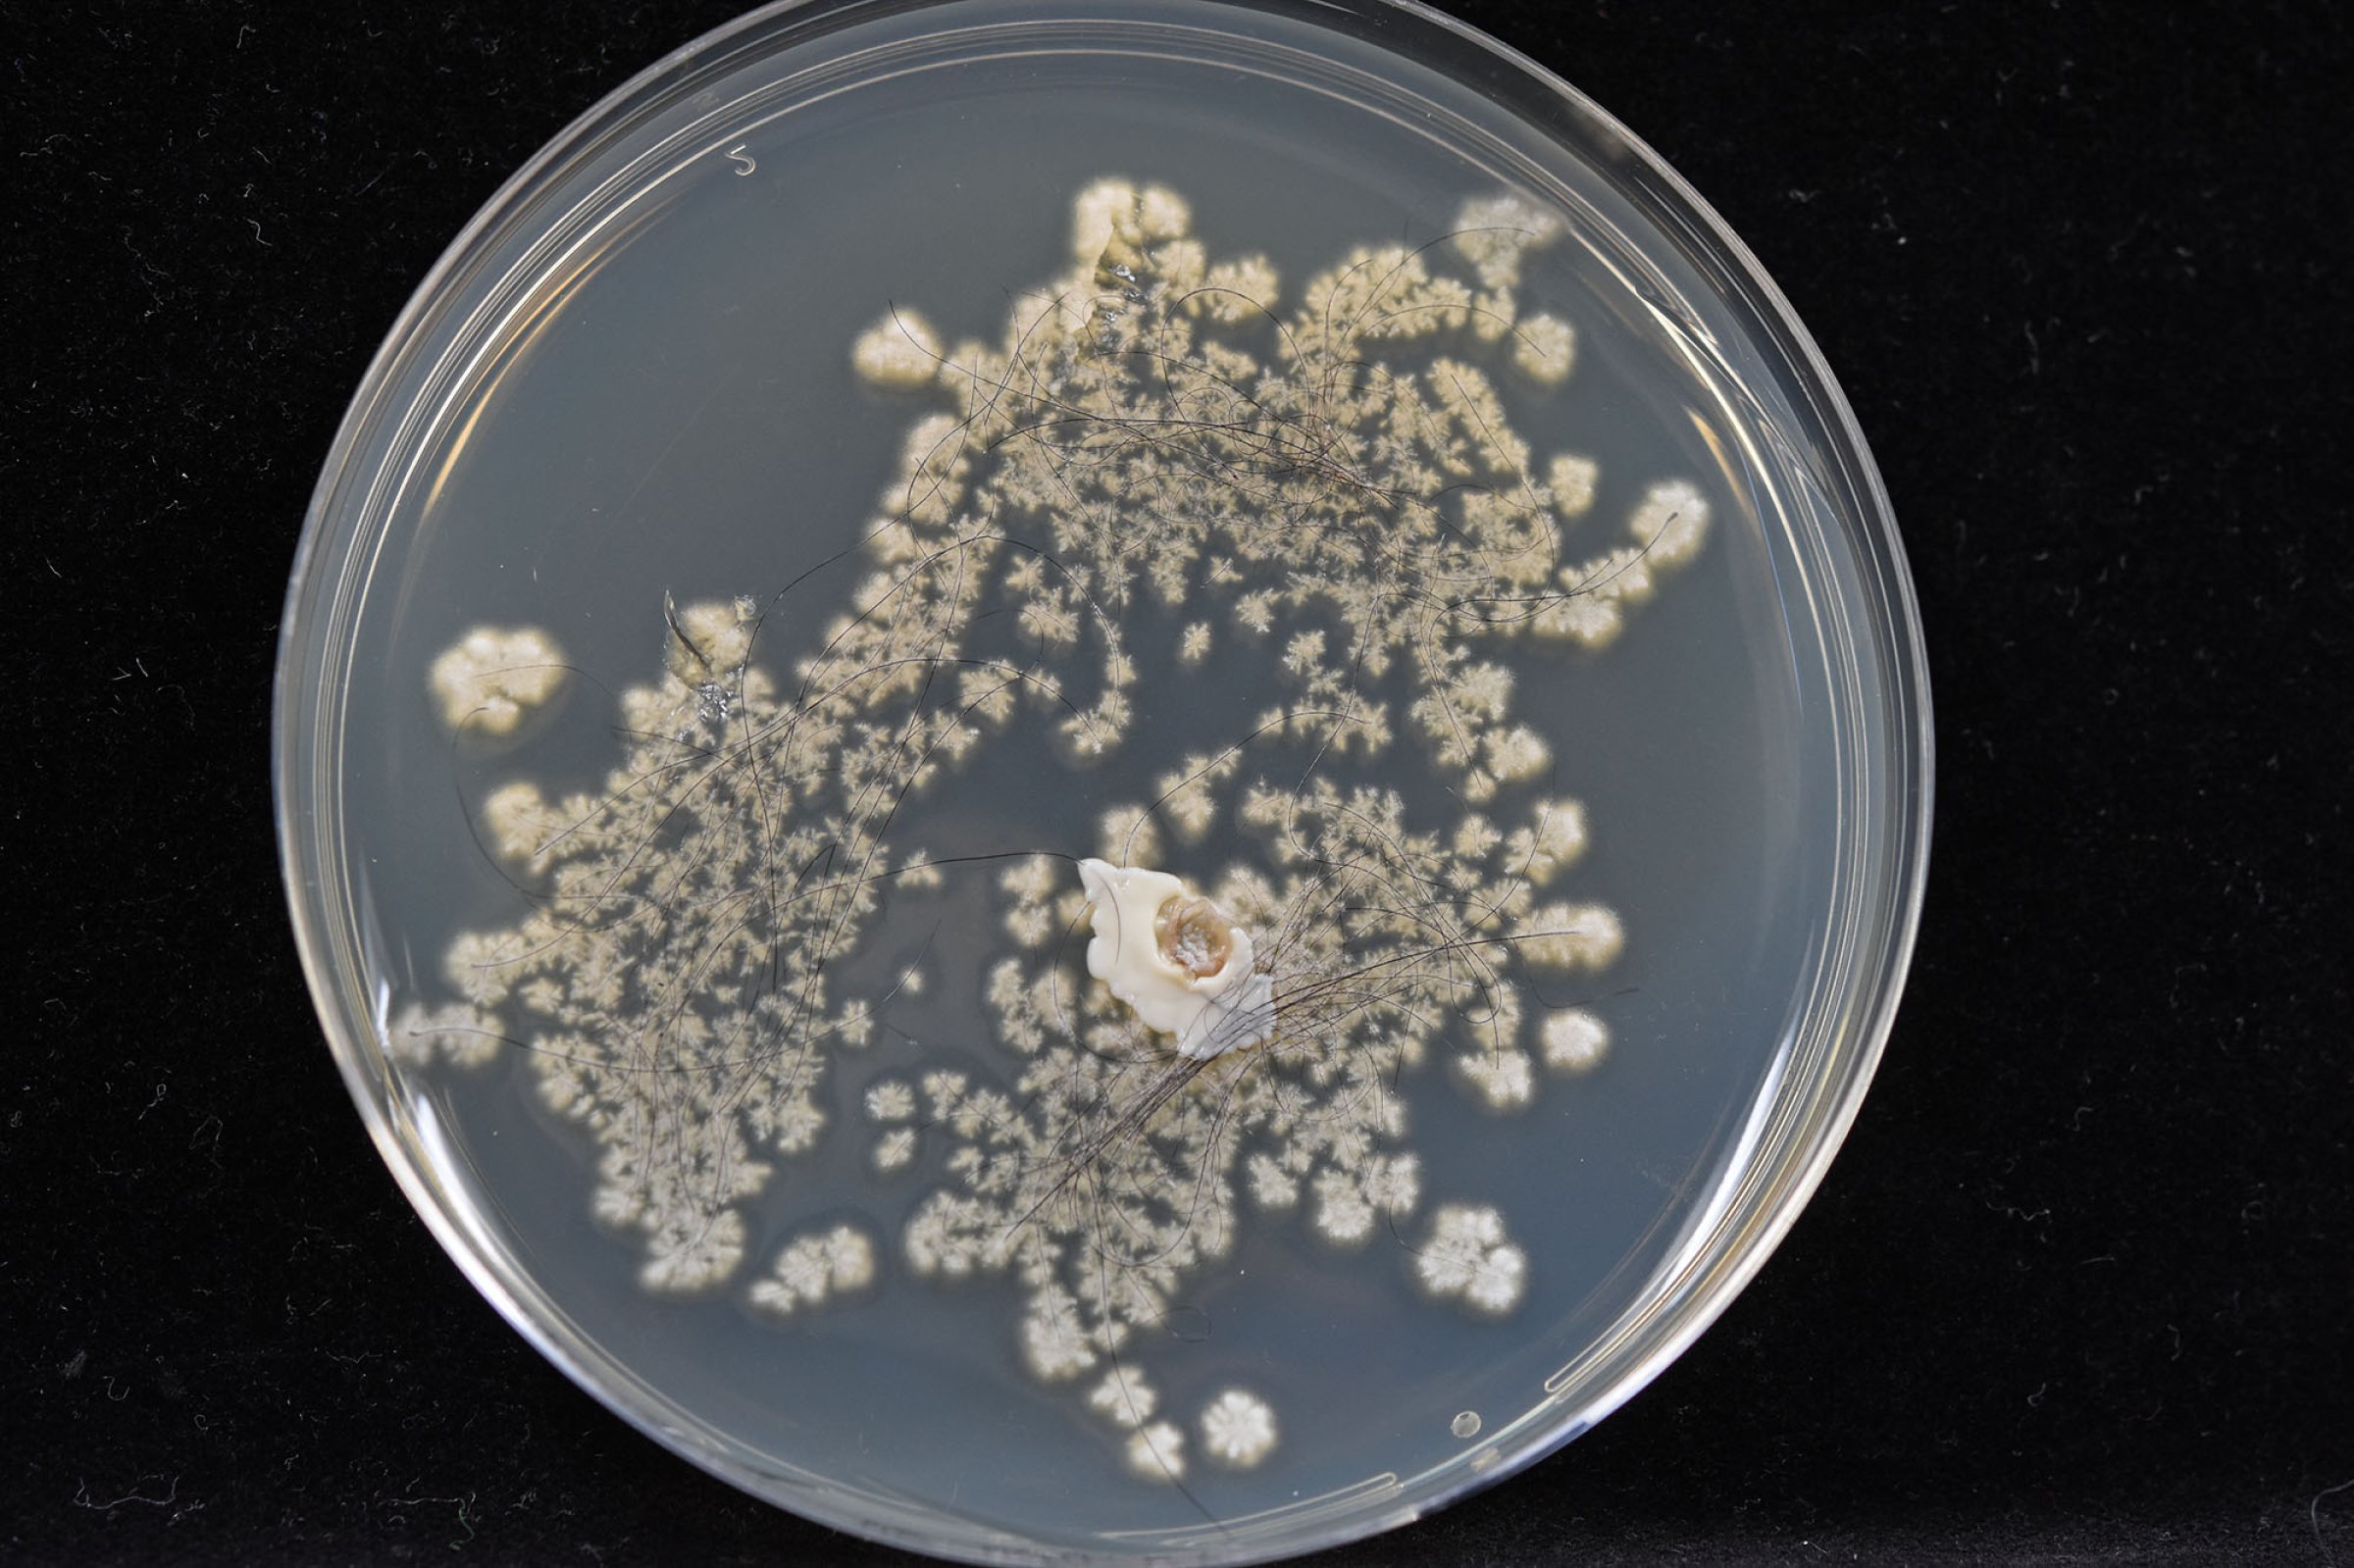

Flere påvisninger av ringorm hos storfe
Veterinærinstituttet har påvist ringorm forårsaket av Trichophyton verrucosum i 15 besetninger av storfe hittil i 2019. Dette er en stigning etter en lengre periode med kun sporadiske tilfeller.
De fleste tilfellene av ringorm er påvist i oktober og november i Rogaland, men den er også påvist i Oppland. Disse tilfellene har hovedsakelig vært i kjøttfebesetninger. Mattilsynet håndterer oppfølging av de smittede besetningene.
På grunn av økning i forekomst oppfordres det til bevissthet rundt denne sykdommen. Symptomene på ringorm i kjøttfebesetningene er til dels svake og vanskeligere å observere, og de kliniske symptomene har variert fra besetning til besetning. I noen er det utbredte tydelige symptomer på mange dyr, mens i andre er symptomene milde og opptrer kun hos få dyr. I slike besetninger er dermed sykdommen vanskeligere å oppdage. Det har vært særlig utfordrende å oppdage symptomer på kjøttferasen Charolais, både på grunn av farge, pels og forekomst av atypiske ringormflekker.
En økning av tilfeller i 2019
For 25 år siden var ringorm forårsaket av T. verrucosum en utbredt sykdom her i landet. Systematisk vaksinasjon og sanering har bidratt til at forekomsten har blitt redusert betraktelig. Den kraftige reduksjonen av ringorm hos storfe på nasjonalt nivå har ført til en økonomisk gevinst både for den enkelte husdyrbruker og for storfenæringen som helhet. Etter en lengre periode med kun sporadiske tilfeller, har antallet påviste tilfeller steget de siste årene.
Sykdommen ringorm
Ringorm er en smittsom soppinfeksjon i det ytterste laget av huden. Sykdommen er utbredt over hele verden, inkludert i våre naboland. Ringorm er en zoonose og kan smitte mellom dyr og mennesker. Den vanligste smittemåten er ved direkte kontakt mellom dyr, som for eksempel ved kjøp og salg av livdyr.
Ringorm hos storfe forårsaket av T. verrucosum er en B-sykdom. Symptomene på ringorminfeksjon kan være svært variable, men det vanligste bildet er håravfall og etterhvert hårløse, ringformede flekker med et flasset eller skorpete belegg, særlig på hodet og halsen. Tiden fra smitte til man får håravfall og flekker på dyra er vanligvis 10-21 dager, men det kan i enkelte tilfeller også ta så lang tid som 6 uker. Infeksjonen kan være plagsom for dyrene. Norge har lenge vært kjent for å produsere storfeskinn av god kvalitet, men slike soppinfeksjoner ødelegger skinnene.
Under gunstige forhold kan T. verrucosum-sporene overleve mange år i miljøet, for eksempel i husdyrrom der det er benyttet treinnredning. For å bli kvitt smitten er det nødvendig med grundig desinfeksjon av miljøet og dyra og vaksinering over en lengre periode.
Ved spørsmål om diagnostikk kan Veterinærinstituttet kontaktes. Ved klinisk mistanke om ringorm forårsaket av T. verrucosum vil diagnostikk ved førstegangspåvisning i besetningen gjøres kostnadsfritt, såfremt det på forhånd er meldt til Mattilsynet.
Aktuelle lenker
Kontaktperson
Thea B. Klem